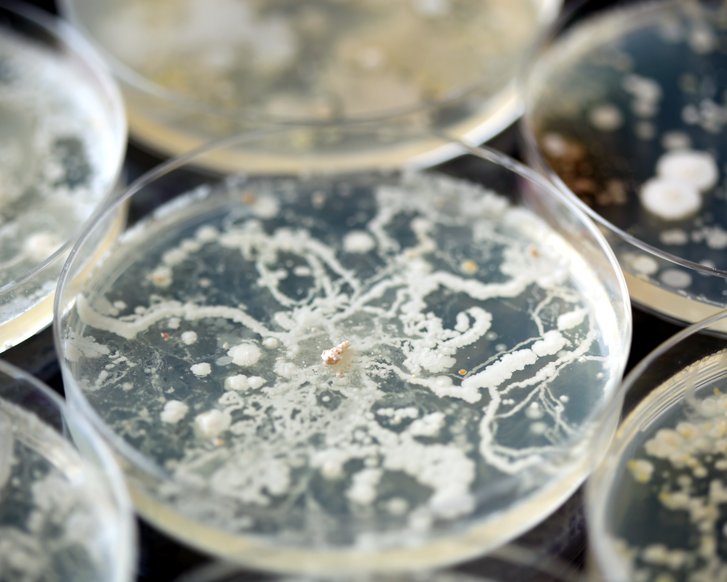
Zahl der Arzneimittel-resistenten Pilze wächst

Zahl der Arzneimittel-resistenten Pilze wächst
Pilzinfektionen müssen zügig erkannt und behandelt werden. Eine Studie zeigt, wie schnell sie sich verbreiten und resistente Stämme entstehen.
Über Bakterienstämme, gegen die gängige Antibiotika nicht mehr wirksam sind, wird viel diskutiert. Denn diese sogenannten Antibiotikaresistenzen stellen ein großes Gesundheitsrisiko dar. Fachleute warnen, dass sich im Bereich der Pilzinfektionen eine ähnliche Entwicklung abzeichnet – die Anzahl der Stämme, die durch Antipilzmittel (Antimykotika) nicht einzudämmen sind, steigt rapide. Eine vermeintlich harmlose Pilzinfektion kann dadurch zu einer großen Gefahr werden. Das gilt vor allem für Menschen mit einem geschwächten Immunsystem, etwa aufgrund ihres hohen Alters, einer Organtransplantation oder einer Krebserkrankung.
Bei einem Krankenhausaufenthalt wandern Pilze leicht zu schwer erkrankten Personen, wie die Studie nachgewiesen hat. Dort besiedeln sie die Haut und den Verdauungstrakt, wo sie teilweise schwere Wund- und Gewebeinfektionen auslösen. Im Extremfall droht eine lebensgefährliche Blutvergiftung (Sepsis) – die Erreger gelangen beispielsweise über einen Katheter in die Blutbahn. Einige Pilz-Stämme haben sich bereits als resistent gegenüber Breitspektrum-Antimyotika wie Fluconazol erwiesen.
Patienten und Patientinnen, die sich mit einem resistenten Pilzstamm infizieren, haben ein dreimal so hohes Sterblichkeitsrisiko wie Personen mit einer Pilzinfektion, die sich mit herkömmlichen Mitteln behandeln lässt.
Detaillierte Studie in Berlin
Das Forschungsteam untersuchte einen langanhaltenden Ausbruch von Infektionen mit azolresistenten C. parapsilosis in mehreren Gesundheitseinrichtungen in Berlin. Dabei stellte sich heraus, dass ein einziger Pilzstamm zu 33 invasiven Infektionen führen (zwischen 2018 und 2022). Der Erreger hatte sich, laut der Analyse der Wissenschaftler und Wissenschaftlerinnen, von Mensch zu Mensch und über verschiedene Einrichtungen hinweg verbreitet.
Die Studie demonstriert, was für eine große Bedeutung es hat, Pilzinfektionen schnell zu erkennen und zu behandeln. Sorgfältige Hygiene-Maßnahmen tragen dazu bei, die Verbreitung der Erreger einzudämmen.
Quellen:

Hier erhalten Sie Tipps zur Behandlung von Hautpilz bei Menschen mit chronischen Wunden.
Dermatomykosen




